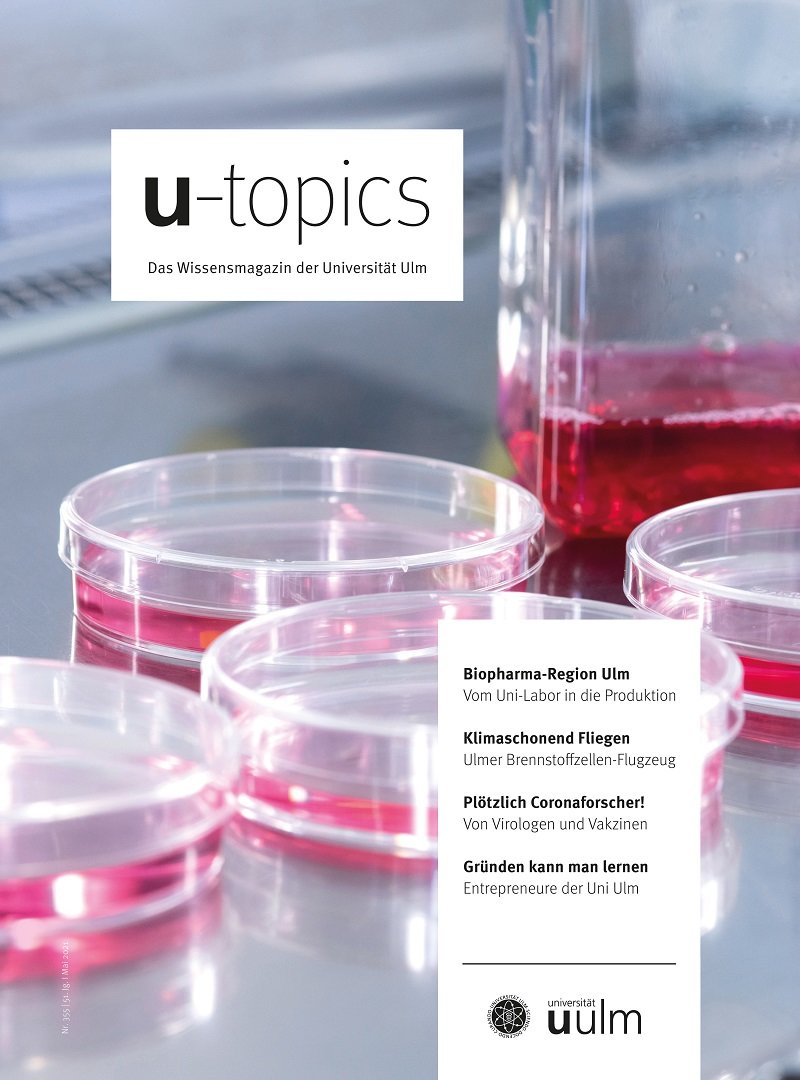

BioPharma Cluster South Germany: Region der Innovationen
Der BioPharma Cluster South Germany ist ein weltweit führender Biotech-Standort und das Herzstück der biopharmazeutischen Entwicklung und Produktion.
Im nationalen Vergleich wird am Standort nahezu die Hälfte der EU-weit zugelassenen biopharmazeutischen Wirkstoffe produziert. Die Region zwischen Ulm und Bodensee zählt zu den umsatzstärksten und bedeutendsten Forschungs-, Entwicklungs- und Produktionsstandorten der pharmazeutischen Industrie in Deutschland. Zum BioPharma Cluster South Germany gehören mehr als 100 Unternehmen und Forschungseinrichtungen aus der Biotechnologie, der Pharmazie und der Medizintechnik.
Der Schwerpunkt der Forschung liegt auf der medizinischen Biotechnologie – auch Rote Biotechnologie genannt. Der Cluster entwickelt vor Ort therapeutische oder diagnostische Verfahren und forscht auf dem Gebiet der personalisierten Medizin. Er leistet somit einen einzigartigen Beitrag zur Medizin der Zukunft.
Einzigartiges Forschungsnetzwerk
Der BioPharma Cluster South Germany verfügt über ein einzigartiges nationales und internationales Forschungsnetzwerk. Vielfältige Kooperationsprojekte zwischen Industrie und Wissenschaft mit hohem Entwicklungspotenzial ebnen den Weg für neue Technologien, Verfahren und Methoden in der medizinischen Biotechnologie. Zu den in der Region angesiedelten Partnern gehören die Universität Ulm sowie die Hochschulen Ulm und Biberach. Der Hochschulverbund InnoSÜD ist Teil der Bund-Länder-Förderinitiative „Innovative Hochschule“.
In den Ulmer ScienceParks haben sich zudem zahlreiche innovative Unternehmen etabliert, darunter erfolgreiche Ausgründungen aus den Hochschulen. Die vom Land Baden-Württemberg und der Wirtschaft gemeinsam getragenen An-Institute verstehen sich als Bindeglied zwischen Forschung und industrieller Entwicklung.
24 Mitglieder des BioPharma Cluster South Germany aus Unternehmen, Wissenschaft und Politk tragen aktiv zu Wachstum und Entwicklung des Clusters bei. Darunter international führende Unternehmen wie Boehringer Ingelheim, Rentschler Biopharma, Sartorius Stedim Cellca, Teva und Vetter.
Hohes Potenzial der medizinischen Biotechnologie
Mit dem BioPharma Cluster South Germany baut Deutschland seine weltweite Führungsposition in der Biotech-Forschung und -Produktion aus. Der Cluster deckt die gesamte biopharmazeutische Wertschöpfungskette ab.
Die Biotechnologie entwickelt sich zu einem Zukunftszweig, der wegweisend für den gesamten Pharmasektor ist. Allein in Deutschland hat sich die Zahl der zugelassenen Biopharmazeutika zwischen 2005 und 2018 verdoppelt. Prognosen zeigen, dass der Anteil personalisierter Biopharmazeutika weiter stark zunehmen wird.
Biopharmazeutika können bereits heute viele Krankheiten lindern oder dauerhaft heilen, für die es früher keine oder nur bedingt erfolgreiche Behandlungsmöglichkeiten gab. Dazu gehören Blutarmut, Multiple Sklerose und Rheuma. In den Bereichen Immunologie, Stoffwechsel, Onkologie und Erkrankungen des zentralen Nervensystems kommen laufend neue Produktinnovationen hinzu.

Wirtschaftsstandort auf Wachstumskurs
Das globale Marktvolumen allein der medizinischen Biotechnologie wird derzeit auf rund 250 Milliarden Euro geschätzt. Mit einem Umsatzwachstum von 10 Prozent rangiert die Biotechnologie damit weit vor den anderen Subsektoren der Gesundheitsindustrie, wie traditionelle Pharmazeutika (rund 3 Prozent) und Medizintechnologie (rund 6 Prozent).
Der BioPharma Cluster South Germany leistet als Wirtschafts- und Forschungsstandort einen zentralen Beitrag zur Wertschöpfung in der Region und in Deutschland. Mit kontinuierlichen Investitionen sind beste Voraussetzungen für weiteres nachhaltiges Wachstum in der Region gegeben.
Attraktiver Unternehmensstandort
Der BioPharma Cluster South Germany steht für eine vielseitige Innovationslandschaft mit starken Partnern. Teva beispielsweise errichtet in Ulm eine neue Biopharma-Produktion für 500 Millionen Euro, während Vetter allein 2018 rund 150 Millionen Euro in moderne Technologien an seinen Standorten investiert hat. Am Standort Biberach baut Boehringer Ingelheim bis 2020 für 230 Millionen Euro ein neues Entwicklungszentrum für biopharmazeutische Medikamente.
Überdurchschnittlich gute Rahmenbedingungen und spezifische Beratungs- und Förderprogramme machen den BioPharma Cluster South Germany für Unternehmen attraktiv. Regionale und kommunale Akteure wie Landkreise und Stadtverwaltungen tragen zu einem innovationsfördernden und dynamischen Umfeld bei.
Der BioPharma Cluster steht Unternehmen als Ansprechpartner für Fragen zu aktuellen Fördermaßnahmen des Bundes, der Länder und der Europäischen Union zur Verfügung. Darüber hinaus unterstützt der Cluster Unternehmen bei der Sondierung geeigneter Projektpartner aus Wirtschaft und Wissenschaft.
Exzellentes Arbeitsumfeld

Der BioPharma Cluster South Germany bietet ein exzellentes Arbeitsumfeld und ausgezeichnete Forschungsbedingungen im Bereich der medizinischen Biotechnologie. Für die Region eröffnet sich dadurch die Chance, diese Zukunftstechnologie auf Jahrzehnte hinaus zu prägen und sich als deren Zentrum nachhaltig und vielseitig zu etablieren.
Wirtschaftlich-wissenschaftliche Kooperationen wie das Boehringer Ingelheim Ulm University Biocenter (BIU) oder die vom Land Baden-Württemberg und der Wirtschaft gemeinsam getragenen An-Institute bieten optimale Voraussetzungen, um die Potenziale der Biotechnologie erfolgreich auszuschöpfen.
Perspektiven und Lebensqualität in der Region
Ob Einkommen, Attraktivität oder Arbeitsmarkt: In vielen Rankings belegt der BioPharma Cluster South Germany vordere Plätze. So rangiert die Stadt Ulm laut „Die große Deutschland-Studie: Wo lebt es sich am besten?“ unter den besten zehn Regionen.
Bereits heute arbeiten mehr als 12.500 Menschen im BioPharma Cluster South Germany. Mit mehr als 5.000 Mitarbeitern betreibt Boehringer Ingelheim in Biberach an der Riss den größten Forschungs-, Entwicklungs- und Biopharmaziestandort des Firmenverbands. Der Cluster gehört damit zu den bedeutendsten F&E-Standorten der pharmazeutischen Industrie in Deutschland. Weltkonzerne und mittelständische Unternehmen bieten Fach- und Führungskräften attraktive Arbeits- und Ausbildungsplätze und hervorragende Perspektiven für die berufliche Entwicklung.
Zwischen Ulm und dem Bodensee gelegen, zeichnet sich der BioPharma Cluster South Germany durch eine hohe Lebensqualität in einer der landschaftlich schönsten Gegenden Deutschlands aus. Ein vielseitiges Freizeit- und Kulturangebot macht das Besondere der Region ebenso aus, wie eine sehr gute Infrastruktur und schnelle Verkehrsanbindung an die Zentren Stuttgart und München sowie in die Alpen oder die Schweiz.
Familien und internationale Fachkräfte finden eine weltoffene und familienfreundliche Atmosphäre und ein großes Angebot an Schulen und Kitas – darunter auch viele internationale Einrichtungen.
Erfahren Sie mehr über die Region der Innovationen